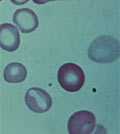
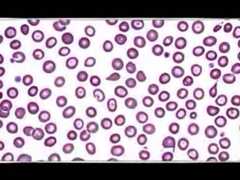

La differenza tra otto e nove
13 dicembre 2025Perché digerisco male?
08 novembre 2025Malattie Mitocondriali: appello alle Istituzioni
19 settembre 2025Xenotrapianto di rene al Massachusetts General ...
10 settembre 2025Rischio annegamento: la campagna Iss
20 giugno 2025Bergamoscienza. Sappiamo deviare un asteroide?
15 ottobre 2022BergamoScienza: «L’etica della comunicazione»
07 ottobre 2022Svenimento, quando è importante andare in Pront...
27 settembre 2020Mal di schiena non traumatico, quando andare in...
23 settembre 2020Come faccio a eseguire un’iniezione sottocutanea
23 settembre 2020Trauma cranico, quando andare in pronto soccorso
22 settembre 2020Come faccio a eseguire un’iniezione intramuscolare
21 settembre 2020Pressione alta, cosa fare? Devo andare in Pront...
18 settembre 2020Celiachia e aumento di peso
15 giugno 2015Intolleranze alimentari
13 aprile 2012Asma allergico: come si cura oggi
21 luglio 2010Vaccini contro l'allergia
20 luglio 2010Allergia alla polvere: come difendersi
16 luglio 2010Fegato grasso, patologia molto diffusa che non ...
02 settembre 2018Tutti gli errori che facciamocon i farmaci per ...
03 settembre 2017Pancreatite cronica, i sintomi e le cure
02 febbraio 2017Cosa fare se il fegato è «grasso»
30 giugno 2014Cos’è la gastrite e come si tratta
31 marzo 2014Come si scopre l'helicobacter pylori
20 gennaio 2014Ernia addominale
23 aprile 2012Colite ulcerosa
26 marzo 2012Che cosa fare se l'intestino è pigro
06 febbraio 2012Se l'intestino è sempre in fiamme
21 novembre 2011Colon irritabile
26 settembre 2011Trauma cranico, quando andare in pronto soccorso
22 settembre 2020La relazione medico-paziente
03 dicembre 2017Quando la scoliosi è grave serve la chirurgia: ...
10 settembre 2017Pressione alta, cosa fare? Devo andare in Pront...
18 settembre 2020Scompenso cardiaco: le cure
12 maggio 2014L'aneurisma dell'aorta addominale
01 luglio 2013I rimedi per le vene varicose
29 aprile 2013Le patologie dell'aorta
11 febbraio 2013Chi sono i dentisti «sentinella»
15 aprile 2019Otturazioni al mercurio
15 ottobre 2007Dente del giudizio: toglierlo o no?
22 giugno 2007I sintomi e i segni del piede diabetico
25 febbraio 2013Diabete di tipo II
12 marzo 2012Prevenzione del diabete
20 febbraio 2012Diabete giovanile e della maturità
09 gennaio 2012Depressione e diabete, quale rapporto?
24 gennaio 2011Diabete: come si riconosce
31 agosto 2010Diabete: il trapianto di cellule pancreatiche
20 dicembre 2008Quando la tiroide funziona troppo
01 febbraio 2008Gli anziani vengono curati con troppi farmaci?
18 novembre 2018Come si inventano i nuovi farmaci?
25 marzo 2018Farmaci tra costo e valore
31 marzo 2015I farmaci generici funzionano davvero?
17 novembre 2014I superbatteri che resistono agli antibiotici
23 settembre 2013Come vanno usati gli antibiotici
01 aprile 2013Antibiotici: le regole per usarli bene
31 agosto 2010Che differenza c’è fra la polmonite batterica e...
19 settembre 2016Ebola, come avviene il contagio
12 dicembre 2014Le zanzare? Ci adorano
30 aprile 2012Test per l'Hiv
28 agosto 2009Tre consigli fondamentali per invecchiare bene
11 febbraio 2019Lo sport che fa bene al cuore
03 marzo 2014Lo sport che fa dimagrire
11 luglio 2013Quando bere se si fa attività fisica
03 giugno 2013Dopo la diagnosi di tumore, come scegliere?
07 novembre 2016Le cadute degli anziani
07 marzo 2016I pregi e i difetti dei medici
17 marzo 2006Svenimento, quando è importante andare in Pront...
27 settembre 2020La mano robotica che sembra vera
02 gennaio 2019Esiste una componente genetica nell’autismo?
16 settembre 2018L’insonnia è di origine genetica?
20 maggio 2018Una donna celiaca può avere problemi di inferti...
09 settembre 2018Carota contro bistecca, chi vincerà?
25 settembre 2017Esiste il cibo «sano»?
27 novembre 2016Come funziona e a che cosa serve il laser
17 dicembre 2017Come si cura oggi la maculopatia?
01 ottobre 2017Intervento di cataratta anticipato
21 giugno 2017Che cos’è il pucker maculare
02 marzo 2015Come si cura oggi la Retinopatia diabetica
05 febbraio 2015I glaucomi: cosa sono e come si curano
22 gennaio 2015Occhio pigro: come riconoscerlo presto
31 agosto 2010Staminali per la cornea
06 novembre 2009Cheratocono: problemi e prospettive
07 agosto 2009La sinusite cronica
28 maggio 2015Che fare se l’orecchio fa male
20 marzo 2014Come si affrontano le vertigini
10 febbraio 2014Mal di schiena non traumatico, quando andare in...
23 settembre 2020Chi cura i reumatismi?
03 marzo 2019Viti e placche nel piede: come si interviene?
23 settembre 2018La chirurgia mininvasiva del piede
30 aprile 2018Il piede piatto nell’adulto
27 marzo 2017Il laser per la neurofibromatosi
26 aprile 2017Chi deve curare la psoriasi
16 marzo 2015Psoriasi: quando si usano i farmaci biologici
11 dicembre 2014L'impatto sociale della psoriasi
10 novembre 2014I problemi che si possono associare alla psoriasi
22 settembre 2014Che cos'è la psoriasi
24 aprile 2014Psoriasi: come si cura
14 aprile 2014Dermatite atopica: cos'è e come si cura
17 ottobre 2011I consigli per la tintarella
18 luglio 2011Unghie specchio della salute
20 novembre 2006Capelli al sole
30 giugno 2006La depressione negli anziani va curata?
12 novembre 2012Gli incontri di Corriere Salute
18 marzo 2012Depressione, quanto conta lo stile di vita?
28 novembre 2010Troppi antidepressivi ai ragazzi?
10 febbraio 2007Non facciamoci prendere dal panico
19 gennaio 2007Come «sopravvivere» alle feste
15 dicembre 2006Pro e contro delle sigarette elettroniche
30 gennaio 2018Il fumo passivo fa male anche all’aperto
18 settembre 2017Spirometria, un esame semplice che dà informazi...
06 settembre 2017Bronchite cronica
12 dicembre 2011Che cosa fare per la tosse?
14 novembre 2011Ozonio: Italia maglia nera
27 giugno 2011Asma: come si cura oggi
31 agosto 2010Prostata ingrossata, quando bisogna operarsi?
30 dicembre 2016La dieta per mantenere sano il rene
23 ottobre 2016Chirurgia robotica per vescica, prostata e rene...
12 settembre 2016Rene, organo "silenzioso" da proteggere
08 ottobre 2012Salvate il soldato rene
16 maggio 2011Sangue nelle urine: le cause
31 agosto 2010Calcoli renali: curarli e prevenirli
11 ottobre 2008Disfunzione erettile: le terapie
02 ottobre 2016Quali sono i rimedi per l’ipertrofia prostatica...
25 settembre 2016Serve ancora fare l'esame del Psa?
22 ottobre 2012Varicocele: attenzione alla fertilità
31 agosto 2010Infertilità maschile
07 giugno 2007Quando l'uomo ha troppa fretta
12 gennaio 2007La prevenzione del tumore al seno
03 ottobre 2017Se l’addome «cede» dopo il parto
04 aprile 2017Mestruazioni abbondanti, come trattarle
19 novembre 2012Come affrontare l'endometriosi?
11 giugno 2012Esami radiologici in gravidanza
28 novembre 2011Incontinenza in gravidanza e dopo il parto
17 gennaio 2011Il caso Messina e i ginecologi
02 settembre 2010Che succede se si «salta» la pillola
22 maggio 2009Terapia ormonale in menopausa
12 settembre 2008Perché vale la pena donare il sangue
14 luglio 2014Globuli bianchi bassi: un problema?
09 gennaio 2011Globuli bianchi alti, quando preoccuparsi?
25 ottobre 2010Anemia falciforme: una nuova emergenza
02 gennaio 2009Anemia mediterranea
28 novembre 2008Le regole del dormire sano
31 agosto 2010Sogni d'oro, per i ricordi
16 maggio 2008Le regole per il sonno perfetto
28 marzo 2008La pastiglia per non dormire
24 marzo 2006Per i tumori del cavo orale il vaccino c’è
27 gennaio 2019Tumore della vescica, come riconoscerlo
20 gennaio 2019Il futuro dell’immunoterapia
12 dicembre 2018La nuova figura del Medical coach
25 febbraio 2018Chirurgia, radioterapia, sorveglianza: come si ...
19 settembre 2017La medicina è un’arte o una scienza?
28 agosto 2017È possibile dilatare la giovinezza?
10 giugno 2018Che cos’è la medicina nucleare?
26 novembre 2017Cure palliative
09 maggio 2012Anticorpi monoclonali
09 aprile 2012LE RUBRICHE DI CORRIERETV
Per la serie «Milano come stai?», il vicedirettore del Corriere della Sera, Venanzio Postiglione...
Milano, affitti e carovita, inquinamento, San Siro, il Pd: incontro con il sindaco Beppe Sala App...
I partiti politici fingono di preoccuparsi per il crescente astensionismo elettorale, promettendo...
Trump, il bagno di sangue e i 454 milioni di dollari mancanti il punto sulla corsa per la Casa Bi...
Un vichingo seminudo, armato di scudo e corna, fugge dalla polizia a bordo di una vasca da bagno ...
Dopo tre anni di esclusione Alternative für Deutschland-Alternativa per la Germania, il partito d...
La crescita dei Green Bond è dovuta principalmente a due fattori: da una parte l’ingresso nel mer...
Denuncia del cancelliere Merz. La Francia:" La UE troppo timida". La Gran Bretagna si è unita al ...
La costellazione dell’Aquila nel cielo d’estate: ecco perché noi siamo figli delle stelle La se...
Gogol, Bulgakov e gli altri: la settima puntata delle «Lezioni sull'Ucraina» di Paolo Mieli «L'U...
Le Serie del Corriere - Operai della bellezza - Milano_Duomo
La banalità del male: cosa rischiamo nelle decisioni di tutti i giorni prese seguendo la corrente...
Un piccolo Paese come la Lituania non può dare noia al gigante cinese La Lituania è finita nella ...
Il revival del governo Conte2 va in scena per una sola notte: ed ecco cosa ha prodotto Consiglio ...
Imprese e persone, le «svolte» possibili e la spinta della formazione continua Nell’evento tenuto...
La fisica bella e difficile (come la poesia cinese) La sesta puntata della Fisica raccontata dal ...
Cinese, albanese e tedesco. Non tutti conoscono queste tre lingue ma tutti potrebbero farsi capir...
Lo chiamano Shadow cricket, cricket ombra: è un modo per allenarsi senza lanciare la palla. Gli a...
Non c'era il bagno di folla a Milano per Snoop Dogg. Ma solo perché le sue guardie del corpo e le...
«Occorre rendersi conto che le manifestazioni di malcontento che si sono verificate nelle carceri...
Il miracolo è quello di giovedì, la medaglia d'oro di supergigante. Dieci mesi dopo un infortunio...
Ammettiamolo: per molti Donald Trump è un narcisista istrione, un folle i cui eccessi – denunciat...
Questo weekend è successo un fatto importante: da Toronto a Los Angeles centinaia di migliaia di ...
Ma che cos’è quest’euro digitale? La cosa è più semplice di quanto appaia. Partiamo dall’inizio, ...
Settembre è da sempre il mese degli iPhone e quest’anno la vera novità si chiama iPhone Air. Non ...
Lo dicono i Lincei: «Da Trump alla Groenlandia, guerre, terre e monete: il ritorno della geopolit...
Uno dei quadri più cari al mondo è questo: si intitola «Shot Sage Blue Marilyn», raffigura una st...